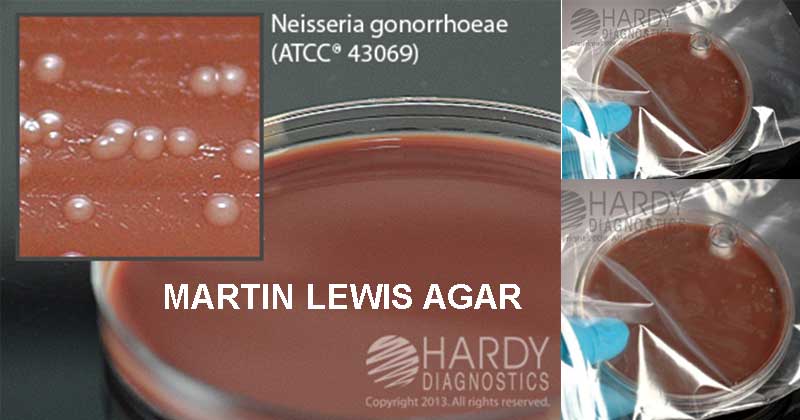
ترکیبات مارتین لوئیس آگار

ابزار و وسایل آزمایشگاهی شامل، محلول ها کیت ها,ویکی ژن
مارتین لوئیس آگار (Martin Lewis Agar): ترکیب، اصول، روش آمادهسازی، نتایج و موارد استفاده
مقدمهای بر مارتین لوئیس آگار
تایر مارتین آگار (Thayer Martin Agar) در سال 1964 برای جداسازی نایسریا گونورهآ (Neisseria gonorrhoeae) و نایسریا مننژیتیدیس (Neisseria meningitidis) توسعه داده شد. در ادامه اصلاحات دیگری روی فرمولهای اولیه این محیط برای بهبود جداسازی گونه بیماریزای نایسریا از نمونههای حاوی مقادیر زیادی فلور میکروبی مخلوط با هم، انجام شد.
مارتین لوئیس آگار فرمولاسیونی است که پس از اصلاح فرمولهای اولیه ساخته شده و حاوی سطح افزایش یافته وانکومایسین جهت مهار بیشتر ارگانیسمهای گرم مثبت است. توسعه محیط کشت مارتین-لوئیس (ML) با یک اصلاح جدیدتر روی فرمول اصلی تایر-مارتین، منجر به افزایش بازیابی گنوکوکها از مواد بالینی شده است.
مارتین لوئیس آگار یک محیط انتخابی و غنیشده برای جداسازی و کشت گونه نایسریا از فلور مخلوط است. هموگلوبین Bio-X و دکستروز گنجانده شده در محیط کشت، مواد مغذی کافی را فراهم کرده تا امکان رشد انبوه میکروارگانیسمهای سختپسند (Fastidious) را فراهم شود.
ترکیبات مارتین لوئیس آگار
| مواد تشکیل دهنده | گرم در لیتر |
| کازئین پپتون (Casein Peptone) | 7.5 |
| میت پپتون (Meat Peptone) | 7.5 |
| نشاسته ذرت | 1 |
| پتاسیم فسفات، دوبازی (Potassium Phosphate, dibasic) | 4 |
| پتاسیم فسفات، مونوبازیک (Potassium Phosphate, monobasic) | 1 |
| کلرید سدیم (Sodium Chloride) | 5 |
| آگار | 10 |
| هموگلوبین | 10 |
| دکستروز | 1.5 |
| غنی ساز Bio-X | 10 میلیلیتر |
| آنتی بیوتیک V.C.A.T | 10 میلیلیتر |
pH در دمای 25 درجه سانتیگراد: 0.2 +/- 7.2
غنی ساز Bio-X
| آب تصفیه شده ویتامین B12 | 0.01 گرم |
| تیامین پیروفسفات (Thiamine Pyrophosphate) | 0.1 گرم |
| ال-گلوتامین (L-Glutamine) | 10 گرم |
| نیترات آهن (Ferric Nitrate) | 0.02 گرم |
| آدنین (Adenine) | 1.0 گرم |
| تیامین هیدروکلراید (Thiamine Hydrochloride) | 0.003 گرم |
| گوانین هیدروکلراید (Guanine Hydrochloride) | 0.03 گرم |
| ال سیستئین هیدروکلراید (L-Cysteine Hydrochloride) | 25.9 گرم |
| p-آمینوبنزوئیک اسید (p-Aminobenzoic Acid) | 0.013 گرم |
| ال سیستین (L Cystine) | 1.1 گرم |
| نیکوتینآمید آدنین دینوکلئوتید (Nicotinamide Adenine Dinucleotide) | 0.25 گرم |
| دکستروز | 100 گرم |
اصول مارتین لوئیس آگار
مارتین لوئیس آگار متشکل از یک پایه آگار شکلاتی است که حاوی پایه GC آگار بهبود یافته، هموگلوبین گاوی و یک غنیکننده شیمیایی تعریف شده است. پایه GC نیز حاوی مواد مغذی نیتروژندار به شکل کازئین و میت پپتونها، بافر فسفات برای حفظ pH و نشاسته ذرت برای خنثی کردن اسیدهای چرب سمی که ممکن است در آگار موجود باشد میباشد.
هموگلوبین هم فاکتور X (همین (Hemin)) را فراهم میکند. غنیسازهای شیمیایی، غنیساز Bio-X، فاکتور V (نیکوتینآمید آدنین دینوکلئوتید – NAD)، ویتامینها، اسیدهای آمینه، کوآنزیمها، دکستروز، یونهای آهن و سایر فاکتورهای لازم برای بهبود و رشد بهینه گونههای بیماریزای نایسریا را فراهم میکنند.
محیط انتخابی شامل عوامل ضد میکروبی وانکومایسین، کولیستین (Colistin)، آنیزومایسین (Anisomycin، مهارکننده V-C-A) و تریمتوپریم (Trimethoprim) برای سرکوب فلور طبیعی است. وانکومایسین عمدتاً علیه باکتریهای گرم مثبت فعال است. کولیستین باکتریهای گرم منفی از جمله گونه سودوموناس (Pseudomonas) را مهار میکند. آنیزومایسین، مخمرها را و تریمتوپریم، پروتئوس (Proteus) را مهار میکند.
روش آمادهسازی مارتین لوئیس آگار
- 36 گرم از محیط خشک شده را در 500 میلیلیتر آب تصفیه و فیلتر شده، بریزید.
- با هم زدن مکرر، آن را حرارت داده و یک دقیقه بجوشانید.
- محیط را در دمای 121 درجه سانتیگراد به مدت 15 دقیقه استریل کنید.
- تا دمای 45 تا 50 درجه سانتیگراد، محیط را خنک کنید.
- 500 میلیلیتر هموگلوبین 2 درصد استریل، 10 میلیلیتر غنیساز Bio-X و 10 میلیلیتر C.A.T اضافه کنید.
- محیط را به آرامی مخلوط کرده و در ظروف پتری (Petri dish) استریل بریزید.
نتایج مارتین لوئیس آگار
مورفولوژی کلنی نوعی در مارتین-لوئیس آگار:

- نایسریا گونورهآ: کلنیهای موکوئیدی (Mucoid) کوچک به رنگ خاکستری مایل به سفید تا بیرنگ.
- نایسریا مننژیتیدیس: کلنیهای موکوئیدی متوسط تا بزرگ، خاکستری آبی.
موارد استفاده از مارتین لوئیس آگار
- مارتین لوئیس آگار یک محیط غنیشده برای جداسازی انتخابی گونههای نایسریا است.
- محیط مارتین لوئیس با لینکومایسین (Lincomycin) یک محیط رشد انتخابی و غنی با وانکومایسین کاهشیافته جهت بازیابی نایسریا گونورهآ از هر دو نمونه تناسلی و اوروفارنکس (Oropharyngeal) فراهم میکند.
محدودیتهای مارتین لوئیس آگار
- آزمایشهای اضافی مانند آزمایشهای مورفولوژیکی، بیوشیمیایی و/یا سرولوژیکی باید برای شناسایی نهایی و تأیید یافتهها انجام شود.
- نایسریا گونورهآ ارگانیسمهای سختپسندی هستند که نسبت به خشکی و دمای شدید حساسیت نشان میدهند. توانایی تشخیص میکروارگانیسمها با این روشهای کشت میتواند تحت تأثیر عوامل زیر باشد: جمعآوری نامناسب نمونه، نگهداری و تلقیح نامناسب، انجام عمل ضدعفونی قبل از جمعآوری نمونه، دما و اتمسفر نامناسب انکوباسیون کشت، طول دوره انکوباسیون کشت نامناسب و مواد نامناسب، نگهداری و جابجایی بیش از حد محیط کشت، نگهداری و جابجایی محیط کشت.
- برخی از سویههای نایسریا گونورهآ ممکن است توسط وانکومایسین و برخی دیگر توسط تریمتوپریم لاکتات (Trimethoprim lactate) مهار شوند.
- برخی از باسیلهای گرم منفی و اکسیداز مثبت در محیطهای انتخابی رشد و کلونیهایی شبیه نایسریا گونورهآ ایجاد میکنند.
جهت خرید و یا استعلام قیمت با ما تماس بگیرید یا در واتسپ پیام بزارید
همچنین بخوانید:
- آگار YEPD: ترکیب، اصول، آمادهسازی، نتایج و موارد استفاده
- محیط کشت لوینتال (Levinthal’s Medium): ترکیب، اصول، روش آمادهسازی، نتایج و موارد استفاده
- پتری دیش چیست؟ تعریف، قطعات، انواع، موارد استفاده
- محیط کشت لون اشتاین جانسون (LJ): ترکیب، اصول، روش آمادهسازی، نتایج و موارد استفاده
- محیط کشت لوفلر (Loeffler Medium): ترکیب، اصول، روش آمادهسازی، نتایج و موارد استفاده
مترجم: صادق حسینیکیا




